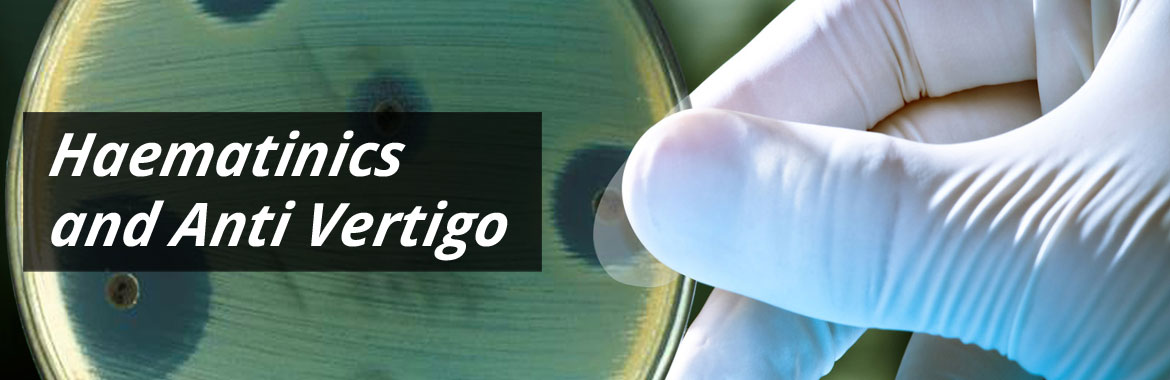
Haematinics and Anti Vertigo

Haematinics & Anti Vertigo » Home
Haematinics & Anti Vertigo

Ferbiron-XT Syp

Redbiron-XT Syp

Redbiron-XT Tab

Votin-8 Tab

Votin 16 Tab
Oue Work
We believe trust builds long lasting relationship with our customers, the ultimate goal of organizational success.

Work that
Matters
What is meaningful work? It's knowing that people the world over rely on us to ensure their

Culture of
Innovation
Good is never good enough. We strive for great and are driven to create ever-improved

Growth & Advancement
We are in the business of advancement, both in health solutions and in the lives and

Livelihood & Well-Being
We attract the best and brightest employees; our benefits packages, compensation plans







